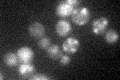
YER072W

View description
Subunit of the vacuolar transporter chaperone (VTC) complex involved in membrane trafficking, vacuolar polyphosphate accumulation, microautophagy and non-autophagic vacuolar fusion
Localization:
Intensity:
Fold change:
Significance:
-
C’ GFP library in SD

ER43.05 -
N' NOP1pr-GFP in SD

vacuole membrane193.027 -
N' TEF2pr-mCherry in SD

ER,vacuole membrane359.45 -
N' NATIVEpr-GFP in SD

vacuole membrane65.7424 -
N' TEF2pr-VC and Cyto-VN in SD

vacuole membrane37.113 -
C’ GFP library in SD+DTT

ER62.171.44Yes -
C’ GFP library in SD+H2O2

ER29.610.68No -
C’ GFP library in Starvation Media
ER33.220.77No -
C’ GFP library on the background of Pup2-DaMP

ER -
C’ GFP library on the background of CCT mutant

ER36.03380.836908No
